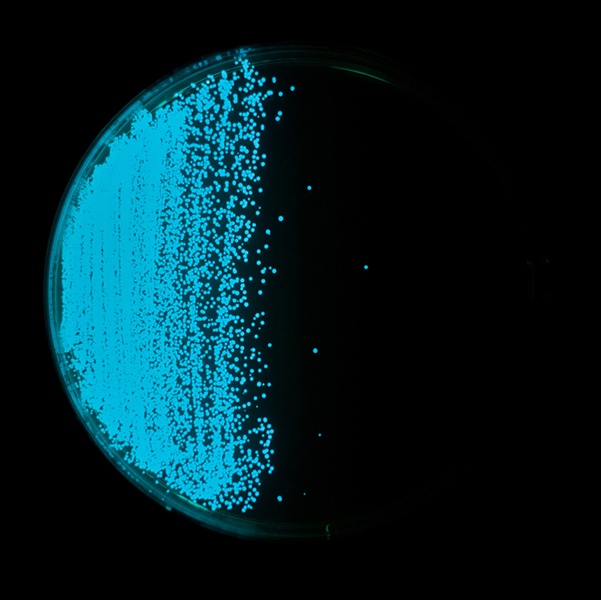

Popular Science, Part 3: Quorum Sensing (English/ Turkish)
What is Quorum Sensing?
Quorum sensing (QS) is a bacterial cell–cell communication process that involves the production, detection, and response to extracellular signaling molecules called autoinducers (AIs). AIs accumulate in the environment as the
bacterial population density increases, and bacteria monitor this information to track changes in their cell numbers and collectively alter gene expression. QS controls genes that direct activities that are beneficial when performed by groups of bacteria acting in synchrony. Processes controlled by QS include bioluminescence, sporulation, competence, antibiotic production, biofilm formation, and virulence factor secretion (reviewed in Novick and Geisinger 2008; Ng and Bassler 2009; Williams and Camara 2009).
https://traveltriangle.com/blog/bioluminescent-beaches-bays-in-the-world/
Quorum sensing was discovered and described over 25 years ago in two luminous marine bacterial species, Vibrio fischeri and Vibrio harveyi. In both species the enzymes responsible for light production are encoded by the luciferase structural operon luxCDABE, and light emission was determined to occur only at high cell-population density in response to the accumulation of secreted autoinducer signaling molecules. Until recently, only a few other cases of bacterial regulation of gene expression in response to cell-cell signaling were known. For example, antibiotic production by Streptomyces spp. , conjugation in Enterococcus faecalis, and fruiting body development in Myxococcus xanthus were also recognized to be controlled by intercellular signaling. These bacterial communication systems were considered anomalous, and in general, bacteria as a whole were not believed to use cell-cell communication. Rather, the exchange of chemical signals between cells/organisms was assumed to be a trait highly characteristic of eukaryotes.
https://www.abyss.com.au/diving/2015/11/what-is-bioluminescence/
GRAM-NEGATIVE BACTERIA: LUXI/LUXR-TYPE QUORUM SENSING
In the past decade quorum sensing circuits have been identified in over 25 species of Gram-negative bacteria. In every case except those of V. harveyi and M. xanthus the quorum sensing circuits identified in Gram negative bacteria resemble the canonical quorum sensing circuit of the symbiotic bacterium V. fischeri. Specifically, these Gram-negative bacterial quorum sensing circuits contain, at a minimum, homologues of two V. fischeri regulatory proteins called LuxI and LuxR. The LuxI-like proteins are responsible for the biosynthesis of a specific acylated homoserine lactone signaling molecule (HSL) known as an autoinducer. The autoinducer concentration increases with increasing cell-population density. The LuxR-like proteins bind cognate HSL autoinducers that have achieved a critical threshold concentration, and the LuxR-autoinducer complexes also activate target gene transcription. Using this quorum sensing mechanism, Gram-negative bacteria can efficiently couple gene expression to fluctuations
in cell-population density.
The Pseudomonas aeruginosa LasI/LasR-RhlI/RhlR Virulence System
In the opportunistic human pathogen P. aeruginosa, a hierarchical LuxI/LuxR circuit regulates quorum sensing. Two pairs of LuxI/LuxR homologues, LasI/LasR and RhlI/RhlR , exist in P. aeruginosa. Both LasI and RhlI are autoinducer synthases that catalyze the formation of the HSL autoinducers N- (3-oxododecanoyl)-homoserine lactone and N-(butryl)-homoserine lactone, respectively. The two regulatory circuits act in tandem to control the expression of a number of P. aeruginosa virulence factors.
The P. aeruginosa quorum sensing circuit functions as follows. At high cell density, LasR binds its cognate HSL autoinducer, and together they bind at promoter elements immediately preceding the genes encoding a number of secreted virulence factors that are responsible for host tissue destruction during initiation of the infection process. These pathogenicity determinants include elastase, encoded by lasB; a protease encoded by lasA; ExotoxinA, encoded by toxA; and alkaline phosphatase, which is encoded by the aprA gene. Analogous to the V. fischeri LuxI/LuxR circuit, LasR bound to autoinducer also activates lasI expression, which establishes a positive feedback
loop.
Figure: The Pseudomonas aeruginosa LasI/LasR-RhlI/RhlR quorum sensing system. P. aeruginosa uses two LuxI/LuxR-like autoinducer-sensor pairs for quorum sensing regulation of a variety of genes. The LasI protein produces the homoserine lactone signaling molecule N-(3-oxododecanoyl)-homoserine lactone (triangles), and the RhlI protein synthesizes N-(butryl)-homoserine lactone (pentagons). The LasR protein binds the LasI-dependent autoinducer when this signal molecule has accumulated to a critical threshold level. Subsequently, the LasR autoinducer complex binds at a variety of virulence factor promoters and stimulates transcription. Additionally, the LasR-autoinducer complex induces the transcription of rhlR to initiate the second quorum sensing circuit. RhlR bound to the RhlI-directed autoinducer activates the transcription of a subset of the LasR-activated virulence genes as well as several target genes that are not regulated by LasR. The LasI autoinducer interferes with binding of the RhlI-autoinducer to RhlR. Presumably, this action ensures that the LasI/LasR circuit is established prior to the establishment of the RhlI/RhlR circuit. The Pseudomonas quinolone signal (PQS) is an additional regulatory link
between the Las and Rhl quorum sensing circuits. The oval represents a bacterial cell. The squares represent the autoinducer synthase proteins LasI and RhlI, and the circles represent the transcriptional activator proteins LasR and RhlR.
GRAM-POSITIVE BACTERIA: PEPTIDE MEDIATED QUORUM SENSING
Gram-positive bacteria also regulate a variety of processes in response to increasing cell-population density. However, in contrast to Gram-negative bacteria, which use HSL autoinducers, Gram-positive bacteria employ secreted peptides as autoinducers for quorum sensing. In general, the peptide is secreted via a dedicated ATP-binding cassette (ABC) transporter. Again, in contrast to the widespread use of LuxR-type proteins as autoinducer sensors by Gram-negative bacteria, Grampositive bacteria use two-component adaptive response proteins for detection of the autoinducers. The signaling mechanism is a phosphorylation/dephosphorylation cascade. A general model for quorum sensing in Gram-positive bacteria is shown in Figure 1.
Figure 1: A general model for peptide-mediated quorum sensing in Gram-positive bacteria. In Gram-positive bacteria, a peptide signal precursor locus is translated into a precursor protein (black and white diamonds) that is cleaved (arrows) to produce the processed peptide autoinducer signal (black diamonds). Generally, the peptide
signal is transported out of the cell via an ABC transporter (gray protein complex). When the extracellular concentration of the peptide signal accumulates to the minimal stimulatory level, a histidine sensor kinase protein of a two-component signaling system detects it. The sensor kinase autophosphorylates on a conserved histidine residue (H), and subsequently, the phosphoryl group is transferred to a cognate response regulator protein. The response regulator is phosphorylated on a conserved aspartate residue (D). The phosphorylated response regulator activates the transcription of target gene(s). The oval represents a bacterial cell. The “P” in the circle represents the phosphorylation cascade. Note that the lengths of the precursor and processed peptides are not meant to signify any specific number of amino acid residues.
QUORUM SENSING IN VIBRIO HARVEYI : A HYBRID HOMOSERINE LACTONE/TWO-COMPONENT SIGNALING CIRCUIT
The V. harveyi quorum sensing circuit possesses features reminiscent of both Gram-negative and Gram-positive quorum sensing systems. Similar to other Gram negative bacteria, V. harveyi produces and responds to an acylated homoserine lactone. In contrast to Gram-negative bacteria, but analogous to Gram-positive bacteria, quorum sensing signal transduction in V. harveyi occurs via a two-component circuit. Additionally, V. harveyi possesses a novel signaling molecule, denoted AI-2. This molecule and the gene required for its production have recently been shown to be present in a variety of Gram-negative and Gram-positive bacteria. AI-2 could be the link that ties together the evolution of the two major classes of quorum sensing circuits.
The V. harveyi Multi-Channel Lux Circuit
Analogous to V. fischeri, V. harveyi, a related free-living marine bacterium, uses quorum sensing to regulate bioluminescence. In V. harveyi two quorum sensing systems function in parallel to control the density-dependent expression of the luciferase structural operon luxCDABE. Each system is composed of a sensor
(Sensor 1 or Sensor 2) and its cognate autoinducer (AI-1 or AI-2) (7, 8). AI-1 is N-(3-hydroxybutanoyl)-homoserine lactone. However, unlike in V. fischeri,synthesis of this HSL autoinducer is not dependent on a LuxI-like protein. The LuxLM protein is required for production of AI-1 and it shares no homology to the LuxI family, although the biosynthetic pathway is probably identical. The structure of the second V. harveyi autoinducer (AI-2) is not known. AI-1 and AI-2 are detected by their cognate sensors LuxN (Sensor 1) and LuxQ (Sensor 2). LuxN and LuxQ are two-component proteins of the hybrid-sensor class. LuxN and LuxQ each contain a sensor kinase domain and a response regulator domain. Another protein, LuxP, is required in conjunction with LuxQ to transduce
the AI-2 signal. LuxP is similar to the ribose binding protein of Escherichia coli and Salmonella typhimurium. LuxN and LuxQ channel phosphate to a shared signal integrator protein called LuxU. LuxU is a phosphotransferase protein, which transfers the signal to a response regulator protein called LuxO.
Figure: The hybrid HSL-two-component quorum sensing circuit of Vibrio harveyi. V. harveyi uses two autoinducers to regulate density-dependent light production. AI-1 is N-(3-hydroxybutanoyl)-homoserine lactone (diamonds), and AI-2 (cylinders) is of unknown structure. The proteins required for synthesis of AI-1 and AI-2 are LuxLM and LuxS, respectively. A cognate two-component sensor kinase protein detects each autoinducer. Specifically, LuxN is responsible for detection of AI-1 and LuxQ is responsible for AI-2. Additionally, a periplasmic binding protein called LuxP is required for AI-2 detection (not pictured). Both LuxN and LuxQ are hybrid sensor kinases that contain a sensor kinase domain and an attached response regulator domain. Signaling from both sensors is channeled to a shared integrator protein called LuxU. LuxU is a phosphotransferase protein that relays the sensory information to the response regulator LuxO. LuxO acts negatively to control the luciferase structural operon luxCDABE. A transcriptional activator called LuxR, which is not similar to the V. fischeri LuxR
family, is also required for expression of luxCDABE. The circuit is proposed to function as follows: At low cell density LuxN and LuxQ autophosphorylate and convey phosphate through LuxU to LuxO. Phospho-LuxO indirectly represses luxCDABE expression. Therefore, no light is produced under these conditions. At high cell density, when LuxN and LuxQ interact with their autoinducer ligands they change from kinases to phosphatases that drain phosphate away from LuxO via LuxU. Unphosphorylated LuxO is inactive. LuxR binds the luxCDABE promoter and activates transcription. Therefore, under these conditions the bacteria produce light.
As a result, bacteria living in different niches have adapted to large QS systems in order to optimize them for the regulation of various activities.
In any case, QS provides the ability to behave in response to the presence of other bacteria on the bacteria and to change behavior.
In addition, new antimicrobial strategies can be designed based on the knowledge gained from QS studies, suggesting that research on QS may have tremendous practical applications.
There is a Bonnie Bassler: How bacteria "talk" | TED Talk.
https://blog.ted.com/the_secret_soci/
https://www.ted.com/talks/bonnie_bassler_on_how_bacteria_communicate
REFERENCES:
QUORUM SENSING IN BACTERIA : Melissa B. Miller and Bonnie L. Bassler Department of Molecular Biology, Princeton University, Princeton, New Jersey 08544-1014; e-mail: mmiller@molbio.princeton.edu, bbassler@molbio.princeton.edu
Bacterial Quorum Sensing: Its Role in Virulence and Possibilities for Its Control Steven T. Rutherford1 and Bonnie L. Bassler1,2 1Department of Molecular Biology, Princeton University, Princeton, New Jersey 08544 2Howard Hughes Medical Institute, Chevy Chase, Maryland 20815 Correspondence: bbassler@princeton.edu
Freeman JA, Lilley BN, Bassler BL. 2000. A genetic analysis of the functions of LuxN: a two-component hybrid sensor kinase that regulates quorum sensing in Vibrio harveyi. Mol. Microbiol. 35:139– 49
https://asknature.org/strategy/bioluminescent-proteins-reduce-solar-damage/#.W0dK4dIzbIU
Tarihçe
Quorum Sensing mekanizması ilk kez bir deniz bakterisi olan V. fischeri ile ilgili araştırmalarda keşfedilmiştir. Bir ilk olması nedeniyle QS mekanizması açısından “V. fischeri” mekanizmayla ilgili model organizma olarak kullanılmıştır.
Zamanla farklı türlerin de aynı mekanizmayı kullandığı fark edilince araştırmalar diğer türlere de yönelmiştir.
-1960
QS mekanizmasına bağlı olarak Açil-homoserin Lakton’larla (AHL) ilgili araştırmalar 1960’lı yılların sonlarında başlamıştır.
İlgili araştırmalarda, bir deniz biyolüminesans bakterisi olan Vibrio fischeri sıvı kültürlerde yetiştirilmekteydi.
Üretildikleri besi ortamında Vibrio fischeri bakterileri bir çeşit ışıma olan biyolimünesans olayına neden oluyorlardı.
Bu kültürlerde ışık oluşumunun yalnızca ortamdaki bakteri sayısının çok fazla olduğu yoğunluklarda meydana geldiği gözlenmiştir (Greenberg, 1997).
-1968
Bu olayla ilgili ilk açıklamalar, “kültür ortamının bir biyolüminesans inhibitörü içerdiği ve bakterilerin ancak ortamdaki sayılarını (popülasyon yoğunluğunu) arttırarak bu inhibitörü ortamdan uzaklaştırabildikleri” şeklindeydi (Kempner & Hanson, 1968).
-1970
Fakat daha sonra limünesans olayının bir inhibitör maddenin ortamdan uzaklaştırılması yoluyla değil de bir aktivatör molekülün (= otoinducer) birikerek artması sonucu meydana geldiği görülmüştür (Nealson ve ark., 1970; Eberhard, 1972).
Bu molekül bakteriler tarafından üretilmektedir ve yeterli konsantrasyon düzeyine ulaştığında lüminesansı aktive etmektedir. İlgili bakteriler otoinducer maddelerin konsantrasyonunu izleyerek hücre yoğunluğunu algılayabilmektedirler. Bu şekilde hücre yoğunluğunu algılama mekanizmasına “quorum-sensing (QS)” denilmektedir.
-1981
V. fischeri tarafından üretilen molekül ilk kez 1981’de Eberhard ve ark. tarafından izole edilmiş, özellikleri belirlenmiş ve N-(3-oxohexanoil)- homoserin lakton (3-oxo-C6-HSL) olarak tanımlanmıştır.
-1983
V. fischeri’ye ait QS mekanizması için gerekli olan genlerin analizi ilk kez 1983’de Engebrech ve ark. tarafından yapılmıştır. Bu çalışma, bugün diğer QS sistemlerime örnek teşkil eden, V. fischeri’deki QS mekanizmasının esas modelini ortaya çıkarmıştır.
Bonnie Bassler, bakterilerin kendilerini savunmalarını, koordine etmelerini ve saldırılara karşı kendilerini korumayı sağlayan kimyasal bir dil kullanarak birbirleriyle “konuştuklarını” keşfetti.
Bulgu, tıp, endüstri ve bizim kendimize olan anlayışımız için çarpıcı etkilere sahiptir.
Aşağıdaki linkten detaylara ulaşabilirsiniz;
https://www.ted.com/talks/bonnie_bassler_on_how_bacteria_communicate
-1990’ların başlarında Nottingham’dan Barrie Bycroft ve Paul Williams, Warwick’ten George Salmond carbapenem antibiyotiklerini üretemeyen Erwinia carotovora mutantlarıyla çalışmaktaydılar.
Amaçları farklı mutantlarda hangi genlerin eksik olduğunu tespit etmek ve biyosentez yolunda gerekli olan bütün genlerin modelini çıkartmaktı.
Bir mutant grubunun sahip oldukları antibiyotiği üretemezken, ikinci bir mutant grubuyla birlikte besi ortamına bırakıldıklarında bu antibiyotiği üretebildikleri gözlendi.
Araştırmalar sonucunda ikinci gruptaki mutantların birinci grupta antibiyotik sentezini tetikleyen bir “sinyal molekülü” nü sentezlediği anlaşılmıştır.
Burada asıl keşfedilen şey söz konusu sinyal molekülünün, Erwinia ile tamamen alakasız bir bakteri olan V. fischeri’de ışık oluşumunu tetiklemek için kullanılan sinyal molekülü ile aynı olmasıdır (Bainton ve ark., 1992).
-1991
Gambello ve Iglewski (1991) insan patojeni Pseudomonas aeruginosa’nın da V. fischeri benzeri QS mekanizmasını kullandığını keşfettiler.
Ancak burada mekanizma ışık oluşumu için değil önemli bir virülans faktör olan “elastaz”ın üretimini düzenlemek için kullanılmaktadır.
Elastazın indüksiyonundan sorumlu AHL, 3-oxo-C12-HSL olarak belirlendi.
-1993
Deniz bakterisi Vibrio’ların haricindeki diğer bakterilerin de AHL bağımlı QS sistemlerini kullandıklarının keşfedilmesi, farklı bakteriler tarafından üretilen AHL’lerin tespit edilmesini sağlayabilen “biyosensör”lerin gelişimine yol açmıştır (Swift ve ark., 1993; Winson ve ark., 1998).
Bu sensörler Enterobakter, Hafnia, Ranella ve Serratia cinslerindeki QS sistemlerini ortaya çıkarmak için kullanılmaktaydı.
O zamandan beri, bu ve benzeri metodlar çok fazla sayıdaki QS türlerini tanımlamak için kullanılmaktadır.
-1995
Rhamnolipid, haemolisin ve diğer önemli virülans faktörlerinin sentezini düzenleyen ikinci bir QS mekanizması da Latifi ve ark. (1995) tarafından bulunmuştur.
Winson ve ark. (1995) bu sistemin C4-HSL üretiminden sorumlu olduğunu gösterdiler. Bu sistem Ochsner ve ark. (1994) tarafından da bağımsız olarak keşfedilmiştir.
Quorum Sensing Mekanizması
Sinyal moleküllerinin algılanması, bakterinin bulunduğu ortamda düşük veya yüksek miktardaki populasyon yoğunluğunu ayırt edebilmesini mümkün kılmakta ve bu sayede ortamda hücre sayısındaki değişikliğe cevap olarak gen ekspresyonunun populasyon düzeyinde kontrolü sağlanmaktadır. Bu olay “Quorum Sensing” olarak ifade edilmektedir.
Başka bir deyimle Quorum Sensing, bir bakteri populasyonunda gen ekspresyonunun, bütün bir popülasyonun gen ekspresyonu dikkate alınarak koordineli bir şekilde gerçekleşmesini ve kontrol edilmesini sağlayan bir iletişim mekanizmasıdır (Schauder ve Bassler, 2001)
QS mekanizması, prokaryot ve ökaryot kavramları arasındaki farkın karıştırılmasına neden olmaktadır.
Çünkü bu mekanizma sayesinde tek hücreli prokaryotik mikroorganizmalar, çok hücreli ökaryotik organizmalar gibi hareket etmekte ve bu da onlara tek başlarına elde edemeyecekleri bir takım avantajlar kazandırmaktadır.
Birçok bakteriyel davranış, QS mekanizmasıyla kontrol edilmektedir.
Simbiyozis, virülans, antibiyotik üretimi ve biyofilm oluşumu bu davranışlardan bazılarıdır.
QS Sinyal Molekülleri
QS mekanizmasında kullanılan sinyal molekülleri türden türe değişmekle birlikte bakterilerin Gram (+) ve Gram (-) olma özelliği dikkate alınarak üç ana gruba ayrılmaktadır. Bunlar;
1. Açil-Homoserin Lakton (AHL veya HSL) türevleri
2. Oligopeptitler
3. Furanosil borat diester türevleri
AHL sinyal molekülleri Gram (-) türler tarafından kullanılırken oligopeptit grubu sinyal molekülleri Gram (+) bakteriler tarafından kullanılır.
Furan türevleri ise bazı Gram (-) veya Gram (+) türlerde ikinci sinyal molekülü olarak görev alır.
QS Mekanizmasının Çeşitleri
QS mekanizmasında kullanılan sinyal moleküllerinin çeşidi ve bu moleküllerin algılanma mekanizmaları dikkate alındığında üç çeşit QS mekanizması vardır (Bassler, 1999);
1. LuxI/LuxR Sistemi [Gram (-) Bakterilerde]
2. Oligopeptit Sistemi [Gram (+) Bakterilerde]
3. Hibrit Sistem [Gram (-) ve Gram (+) Bakterilerde ]
QS Mekanizmasında Görevli Genler ve Gen Anlatımının Düzenlenmesi
Bir bakteri türünün QS mekanizmasını kullanabilmesi, diğer bir ifadeyle kültürde bulunan bakterilerin populasyon yoğunluğuna bağlı olarak davranış değiştirmeleri, bu mekanizmayla ilgili genlere/operonlara sahip olmaları ile mümkündür.
Dolayısıyla her bir tür QS mekanizmasıyla ilgili olarak kendi türüne özgü genleri kullanmaktadır.
Bu genlerin ifade edilmesi çoğunlukla operon halinde gerçekleşmektedir.
QS mekanizmasıyla ilgili bulunan ilk genler V. fischeri‘ye ait olan lux I/lux R genleridir. V. fischeri’de biyolüminesans olayının gerçekleşmesini kontrol eden ve ilk kez bulunması nedeniyle model sistem olarak kabul edilen LuxI/LuxR sisteminde, her bir gen, sürecin baştan sona eksiksiz gerçekleşmesini sağlayan moleküllerin/yapıların oluşumu için gerekli genetik bilgiyi taşımaktadır.
LuxI ve LuxR Protein Ailesinin Fonksiyonları
QS mekanizmasına yönelik çalışmalarda, bu mekanizmayla ilgili genin/genlerin belirlenmesi başlı başına bir araştırma alanıdır.
Bu bağlamda, sinyal moleküllerini ve/veya sinyal moleküllerini kodlayan enzim sistemlerini (Li ve ark., 2004; Otto, 2001), algılama sistemlerini ve/veya bu sistemleri sentezleyen enzim sistemlerini (Freeman ve Bassler, 1999; Mok ve ark., 2003) kodlayan genleri belirlemek amacıyla ayrı ayrı çalışmalar yapılmış ve uygulamaya yönelik veriler elde edilmiştir.
Pseudomonas aeruginosa LasI/LasR-RhlI/RhlR Virülans Sistemi
LasI ve RhlI → autoinducer
N-(3-oxododecanoyl)-homoserine lactone ve N-(butryl)-homoserine lactone.
P. aeruginosa virülans faktörünün ekspresyonunu kontrol etmek için birlikte çalışır.
Yüksek hücre yoğunluğunda, LasR kendi HSL oto-indükleyicisine bağlanır ve birlikte, enfeksiyon sürecinin başlatılması sırasında konakçı doku tahribatından sorumlu olan bir dizi salgılanmış virülans faktörlerini kodlayan genlerden hemen önce promotör elemanlarına bağlanır.
Bu patojenite belirleyicileri, lasB tarafından kodlanan elastazı; lasA tarafından kodlanan bir proteaz; ToxA tarafından kodlanan ExotoxinA; ve aprA geni tarafından kodlanan alkalin fosfatazı sentezlerler.
RhlR,RhlI tarafından üretilen oto-indükleyiciyi bağlar; Bu kompleks aynı zamanda LasI / LasR sisteminin kontrolü altında olan iki genin ekspresyonunu indükler, LasB ve AprA.
Ek olarak, RhlR-otoindüser kompleksi, ikinci bir spesifik hedef gen sınıfını aktive eder.
Bu genler, sigma faktörü kodlayan RpoS içerir; rhamnosiltransferazı kodlayan ve biyosürfaktan / hemolizin rhamnolipid sentezinde rol oynayan RhlAB; piyosiyanin antibiyotik sentezinde rol oynayan genler.
LasR-otoindüser kompleksi, ikinci sinyalleşme kaskadını başlatmak için rhlR ifadesini aktive eder. Bununla birlikte, LasR'ye bağımlı oto-indükleyici, N (3-oksododekanoil) -homoserin lakton, aynı zamanda RhlI'ye bağımlı oto-indükleyicinin, N- (butril) -homoserin laktonun kendi regülatörü RhlR'ye bağlanmasını da önler.
Muhtemelen, LasI / LasR sistemi tarafından RhlI / RhlR otoindüksiyonunun bu ikinci kontrol seviyesi, iki sistemin kademeli olarak ve uygun sırada kaskadlarını başlatmasını sağlar.
Gram (+) Bakterilerde Peptit Aracılığı ile QS
HSL oto-indükleyicilerini kullanan Gram-negatif bakterilerin aksine, Gram pozitif bakteriler, QS için oto-indüktörler olarak salgılanan peptitleri kullanırlar.
Genel olarak peptit, özel bir ATP bağlayıcı kaset (ABC) taşıyıcı vasıtasıyla salgılanır. (ABC (ATP Bağlayıcı Kaset) taşıyıcı ailesi üyeleri transmembran proteinleri olup enerjiye bağımlı olarak çalışırlar.)
Gram (-) bakterilerin oto-indüktör sensörleri olarak LuxR-tipi proteinlerin yaygın kullanımının tersine, Gram (+) bakteriler, oto-indüktörlerin tespiti için iki bileşenli adaptif yanıt proteinleri kullanırlar.
Sinyalleşme mekanizması fosforilasyon / defosforilasyon kaskadıdır.
Gram-pozitif bakterilerde, bir peptit sinyal öncüsü lokusu, işlenmiş peptit oto-indüktör sinyalini üretmek üzere bir prekürsör proteine çevrilir.
Genel olarak peptit sinyali, bir ABC taşıyıcısı yoluyla hücrenin dışına taşınır.
Peptit sinyalinin hücre dışı konsantrasyonu minimal stimülatör seviyeye ulaştığında, histidin sensor kinaz proteini onu algılar.
Yanıt regülatörü, korunmuş Aspartat üzerinde fosforile edilir.
Fosforillenmiş yanıt düzenleyici, hedef gen(ler)in transkripsiyonunu aktive eder.
Gram-pozitif bakterilerde temel sinyal mekanizması korunmuştur.
Ancak, belirli bir ortam için sinyal iletim sürecinin etkinliğini arttırmak için sistemlerin regülasyon / zamanlamalarındaki farklılıklar ortaya çıkmıştır.
Vibrio harveyi QS Sistemi
V. harveyi QS sistemi, hem Gram-negatif hem de Gram-pozitif QS sistemlerini anımsatan özelliklere sahiptir.
Diğer Gram negatif bakterilere benzer şekilde, V. harveyi açil HSL üretir ve buna yanıt verir.
Gram-negatif bakterilerin aksine, Gram-pozitif bakterilere benzer şekilde, V. harveyi'de QS sinyal iletimi iki bileşenli bir devre ile gerçekleşir.
Ek olarak, V. harveyi, AI-2 olarak adlandırılan yeni bir sinyal molekülüne sahiptir.
Bu molekülün ve üretimi için gerekli olan genin son zamanlarda çeşitli Gram-negatif ve Gram-pozitif bakterilerde mevcut olduğu gösterilmiştir.
AI-2, iki ana QS sistemi evrimini birbirine bağlayan bağlantı olabilir.
AI-1, N- (3-hidroksibütanoil) -homoserin laktondur ve AI-2, bilinmeyen bir yapıya sahiptir.
AI-1 ve AI-2'nin sentezi için gerekli olan proteinler sırasıyla LuxLM ve LuxS'dir.
İki bileşenli sensör kinaz proteini, her bir oto-indüktörü algılar. Spesifik olarak, LuxN, AI-1'in saptanmasından sorumludur ve LuxQ, AI-2'den sorumludur.
Ek olarak, AI-2 saptaması için LuxP olarak adlandırılan bir periplazmik bağlayıcı protein gereklidir.
Her iki sensörden gelen sinyal, LuxU entegratör proteinine yönlendirilir.
LuxU, bilgiyi cevap düzenleyici LuxO'ya ileten bir fosfotransferaz proteindir.
LuxO, lusiferaz yapısal operon luxCDABE'yi kontrol etmeye olumsuz etki eder.
LuxCDABE'nin ifadesi için V. fischeri LuxR ailesine benzemeyen LuxR adlı bir transkripsiyon aktivatörü de gereklidir.
LuxN ve LuxQ düşük hücre yoğunluğunda otofosforillenir ve LuxU'dan LuxO'ya fosfat iletir.
Fosfo-LuxO, luxCDABE ifadesini dolaylı olarak bastırır.
Bu nedenle, bu koşullar altında hiç ışık üretilmez. Yüksek hücre yoğunluğunda, LuxN ve LuxQ, kendi oto-indükleyici ligandları ile etkileştiğinde, kinazlardan LuxU ile LuxO'dan fosfatları süzen fosfatazlara dönüşürler.
Fosforlanmamış LuxO aktif değildir. LuxR luxCDABE promotörünü bağlar ve transkripsiyonu aktive eder. Bu nedenle, bu koşullar altında bakteri ışık üretir.
Sonuç olarak, farklı nişlerde yaşayan bakteriler, çeşitli aktivitelerin düzenlenmesi için bunları optimize etmek üzere geniş çaplı QS sistemlerine adapte olmuşlardır.
Her durumda QS, bakteri üzerinde diğer bakteri varlığına yanıt olarak davranma ve davranış değiştirme yeteneği sağlar.
Ayrıca, yeni antimikrobiyal stratejiler, QS üzerine yapılan araştırmaların muazzam pratik uygulamalara sahip olabileceğini düşündüren, QS çalışmalarından elde edilen bilgilere dayanarak tasarlanabilir.

.jpg)





















Congratulations! This post has been upvoted from the communal account, @minnowsupport, by hurcell from the Minnow Support Project. It's a witness project run by aggroed, ausbitbank, teamsteem, theprophet0, someguy123, neoxian, followbtcnews, and netuoso. The goal is to help Steemit grow by supporting Minnows. Please find us at the Peace, Abundance, and Liberty Network (PALnet) Discord Channel. It's a completely public and open space to all members of the Steemit community who voluntarily choose to be there.
If you would like to delegate to the Minnow Support Project you can do so by clicking on the following links: 50SP, 100SP, 250SP, 500SP, 1000SP, 5000SP.
Be sure to leave at least 50SP undelegated on your account.